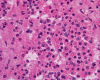

Squash
Squash
Frozen
Camtu Truong,
M.D., Rhonda Shuey-Drake, M.S., Kar-Ming Fung, M.D., Ph.D.
Last update: September 30, 2005.
A 60 year-old Man with a
Pituitary Mass.
October, 2005, Case 510-1.
Home Page
Department of Pathology, University of Oklahoma Health Sciences Center, Oklahoma City, Oklahoma
Clinical information: The patient was a 60 year-old man who presented with blurred vision and headache. On MRI scan, a macroadenoma was identified in the pituitary gland. The patient had no evidence of acromegaly. The hormone profile in his periphery blood was within normal limits. The tumor was surgically removed and the followings are the representative sections:
 |
 |
|
 |
 |
 |
 |
|
A. Squash |
B. Squash |
C. Frozen |
D. | E. | F. | G. |
Pathology of the case:
Light microscopy: In the cytologic preparation for intraoperative consultation, there are many round, monotonous, and naked nuclei (Panel A and B). In the small number of intact cells, there is a moderate amount of bright eosinophilic cytoplasm (Panel B). On the frozen section, the cells appear to have moderate to large amount of coarsely granular, eosinophilic cytoplasm (Panel C). On formalin fixed, paraffin embedded sections (Panel D), the lesion is composed of sheets of polygonal cells with a moderate amount of eosinophilic cytoplasm. In some area, these cells have a mosiac pattern of arrangement. There is a mild degree of variation of cell size and nuclear size. No mitotic figures are found and there was no necrosis. On immunohistochemistry, the cells are non-immunoreactive for growth hormone (GH), prolactin, luteinizing hormone, adrenal cortical trophic hormone (ACTH), follicle stimulating (FSH), thyroid stimulating hormone (TSH).
Electron microscopy: A substantial amount of mitochondria is present in the cytoplasm (Panel E and F). Admixed with the mitochondria are some small vesicles that typically have a dense core surrounded by a thin halo (Arrow in Panel E and F) and these are scare neuroendocrine (dense core) granules. Many of the mitochondria are also swollen (Panel G) and this feature may be a genuine feature or a result of mild artifact due to slight delay in fixation.
Comment: The features of the lesion is that of a pituitary oncocytoma. Similar to other pathologic processes with oncocytic changes, there is an increase in variation of nuclear size which would may suggest malignancy particularly on frozen sections. Recognition of the coarse granular, eosinophilic cytoplasm is a helpful clue. Electron microscopy confirmed that the oncocytic changes are resulted from a substantial amount of mitochondria. Identification of the neurosecretory (dense core) granules, confirmed the neuroendocrine of these cells. Similar to many other pituitary oncocytomas, there is no immunoreactivity for the hormone panel that we have tested.
| DIAGNOSIS: Pituitary oncocytoma (Null cell adenoma with extensive oncocytic changes). |
Discussion: General Information Clinical Information Pathology Differential diagnosis
General Information
Pituitary adenomas comprises a family of tumors with diversified hormonal phenotypes, including somatotroph adenoma, prolactinoma, mixed somatotroph and lactotroph adenoma, acidophil stem cell adenoma, mammosomatotroph adenoma, corticotroph adenoma, thyrotroph adenoma, gonadotroph adenoma, null cell adenoma, oncocytoma and unclassified adenomas. Their hormonal phenotype is determined by both immunohistochemistry and electron microscopy 1.
Null cell adenomas do not possess the immunocytochemical and ultrastructural features to indicate hormone production. It may have originated from hormone secreting cells which lost its ability to produce hormone production during neoplastic transformation. The origin of null cell adenomas, however, is not exactly certain. The term null cell adenoma was first proposed by Kovacs et al., in 1980 2. These tumors have also been termed “undifferentiated cell adenomas”. This term, however, is inappropriate and is not being used currently. Oncocytoma is essentially a subtype of null cell tumor and does not produce hormone and has the additional feature of oncocytic changes on light microscopy and substantial number of mitochondria in the cytoplasm under the electron microscope.
As oncocytoma is a variant of null cell adenoma, they share similar clinical features and prognosis. The incidence of oncocytomas and null cell adenomas are 6 and 17% respectively 3. Oncocytomas are more common in elderly patients with peak incidence in the sixth decade of life and has a strong predilection for males. It is uncommon in patients older than 70 and younger than 40 years of age 3, 4, 5, 6, 7.
As no hormone is produced by null cell adenomas and oncocytomas, they are not associated with clinical manifestations resulted from hormone over production. It is of no surprise non-functional pituitary adenomas including null cell adenomas and oncocytomas are usually noticed after they have advanced into a mass of considerable size, causing symptoms of mass effect such as visual loss, headaches and hypopituitarism 8, 9. The “stalk effect” can cause modest and asymptomatic hyperprolactinemia in these patients by suppressing prolactin inhibiting factors’ production and release. Otherwise, these tumors do not produce any increase in serum hormone levels.
While null cell adenomas typically occur as a chromophobe adenoma. They show negativity with carmoisine, periodic acid-Schiff (PAS), lead hemtoxylin or other basic dyes. Oncocytomas are composed of sheets of oval cells with eccentric nuclei and moderate amount of bright eosinophilic, granular cytoplasm with hematoxylin-eosin stain. Oncocytic transformation may not be complete and the proportion of oncocytic cells may vary from sporadic cells to oncocytic clusters to complete oncocytic transformation. Similar to other adenomas, the cells can arrange into diffuse solid sheets, pseudopapillary pattern, rosette formation and other patterns. The oncocytic cytoplasm stains dark blue with phosphotungstic acid hematoxylin (PTAH). As the oncocytic changes produces bright eosinophilic cytoplasm, PTAH is rarely needed for its detection. Similar to oncocytic changes occurring in other organs such as the mammary glands, cells with oncocytic changes are associated with increase cytologic atypia. The nucleoli are not prominent. The increase pleomorphism is not an indication of aggressive behavior. However, it may be a disturbing feature during intraoperative cytologic and frozen section consultation 2, 3, 5, 6.
Although, no hormone production is usually detected by immunostaining in both null cell adenomas and oncoctytomas, immunostaining for thyrotrophin stimulating hormone, follicle stimulating hormone, luteinizing hormone, prolactin, growth hormone and/or alpha-subunit of glycoprotein hormones may show positivity in a few scattered cells. Tumor cells of both null cell adenomas and oncocytomas show positivity with neuron-specific enolase (NSE), chromogranin A and synaptophysin 10, 11, 12, 13, 14.
The oncocytic change does not appear to be associated with increase cellular proliferation or invasion 5, 14. How much oncocytic changes are required to grant a diagnosis of oncocytoma? There is no clear cut guideline. For many investigator, oncocytic changes in over 50% of the adenoma cells having oncocytic features is required but some investigators requires complete transformation before a diagnosis of oncocytoma is made 2, 14.
Under the electron microscope, the cytoplasm of oncocytoma is filled with mitochondria. A sparse number of neurosecretory granules (dense core granules) can also be seen. Both features are illustrated in our case.
Differential diagnosis
Histologic distinction between pituitary oncocytoma and other tumor in that location is usually straight forward. The only except is granular tumor arising in the posterior pituitary which may mimic oncocytoma because of its granular cytoplasm.
Granular cell tumors of the neurohypophysis are most often asymptomatic and found as incidental findings in autopsy and their frequency increase with age. Symptomatic tumors are rather uncommon. The cytologic features are similar to granular tumors arising in other parts of the body. In common, they are composed of solid sheets of polygonal cells with a granular cytoplasm and bland nuclei. Although the cytoplasm is granular, they are not as brightly eosinophilic as in pituitary oncocytoma. On periodic acid-Schiff (PAS) stain, cytoplasms of granular cell tumors are strongly positive. Positive immunoreactivity for S100 protein and GFAP has been described in some but not all granular tumors 15.
A newly described entity, spindle cell oncocytoma, can be confused with pituitary oncocytoma morphologically. However, spindle cell oncocytoma does not appear to have phenotype of pituitary adenomas. In essence, spindle cell oncocytoma appear to be a benign tumor for the small number of cases that have been reported and they occur in adults in the 6th to 8th decade. They appear as fascicles of spindle cells with eosinophilic, granular cytoplasm. They are negative for pituitary hormones, synaptophysins, chromogranin, and glial fibrillary acidic protein. However, they are positive for vimentin and S-100 protein. Although a large number of mitochondria can be demonstrated under the electron microscope, they do not possess neurosecretary granules (dense core granules) 16.
Reference:
Horvath E, Kovacs K. Pituitary gland. Path Res Pract 1988 183:129-142
Kovacs K, Horvath E, Ryan N, Ezrin C. Null cell adenoma of human pituitary. Virchows Arch A Path Anat HIstol 1980 387:165-174
Holm R. Null cell adenomas and oncocytomas of the pituitary gland. Pathol Res Pract 1995 191:348-52
Kurosaki M, Saeger W, Ludecke DK. Pituitary tumors in the elderly. Pathol Res Pract 2001197:493-7
Niveiro M, Aranda FI, Paya A, Boix E, Peiro G, Pico A. Oncocytic transformation in pituitary adenomas: immunohistochemical analyses of 65 cases. Arch Pathol Lab Med 2004128:776-80.
Giangaspero F, Cenacchi G. Oncocytic and granular cell neoplasms of the central nervous system and pituitary gland. Semin Diagn Pathol 1999 16:91-7.
Yamada S, Kovacs K, Horvath E, Aiba T. Morphological study of clinically nonsecreting pituitary adenomas in patients under 40 years of age. J Neurosurg 1991 75:902-905
Ebersold MJ, Quast LM, Laws ER Jr, Scheithauer B, Randall RV. Long term results in transphenoidal removal of nonfunctioning pituitary adenomas. J Neurosurg 1986 64:713-719
Silbergeld DL, Mayberg MR, Berger MS, Ali-Osman F, Kelly WA, Shaw CM. Pituitary oncocytomas: clinical features, characteristics in cell culture, and treatment recommendations. J Neurooncol 1993 16:39-46
Martinez AJ. The pathology of nonfunctional adenomas. Sem Diagn Pathol 1986 3:83-94
Holm R, Nesland JM, Attramadal A, Halse J, Johannessen JV. Null cell adenomas of the pituitary gland. An immunohistochemical study. J Pathol 1989 158:213-21
Asa SL, Ryan N, Kovacs K, Singer W, Marangos PJ. Immunohistochemical localization of neuron-specific enolase in human hypophysis and pituitary adenomas Arch Pathol Lab Med 1984 108:40-43
Schmid KW, Kroll M, Hittmair A, Maier H, Totsch M, Gasser R, Finkenstett G, Hogue-Angeletti R, Fischer-Colbrie R. Chromogranin A and B in adenomas of the pituitary. An immunohistochemical study of 42 cases. Am J Surg Pathol 1991 15:1072-1077
Nishioka H, Ito H, Hirano A, Shibata N, Kobayashi M. Immunocytochemical study of pituitary oncocytic adenomas. Acta Neuropathol 1997 94:42-47
Nishioka H, Ii K, Llena JF, Hirano A. Immunohistochemical study of granular cell tumors of the neurohypophysis. Virchows Arch B Cell Pathol Incl Mol Pathol 1991 60:413-7.
Roncaroli F, Scheithauer BW, Cenacchi G, Horvath E, Kovacs K, Lloyd RV, Abell-Aleff P, Santi M, Yates AJ. 'Spindle cell oncocytoma' of the adenohypophysis: a tumor of folliculostellate cells? Am J Surg Pathol 2002 26:1048-55.